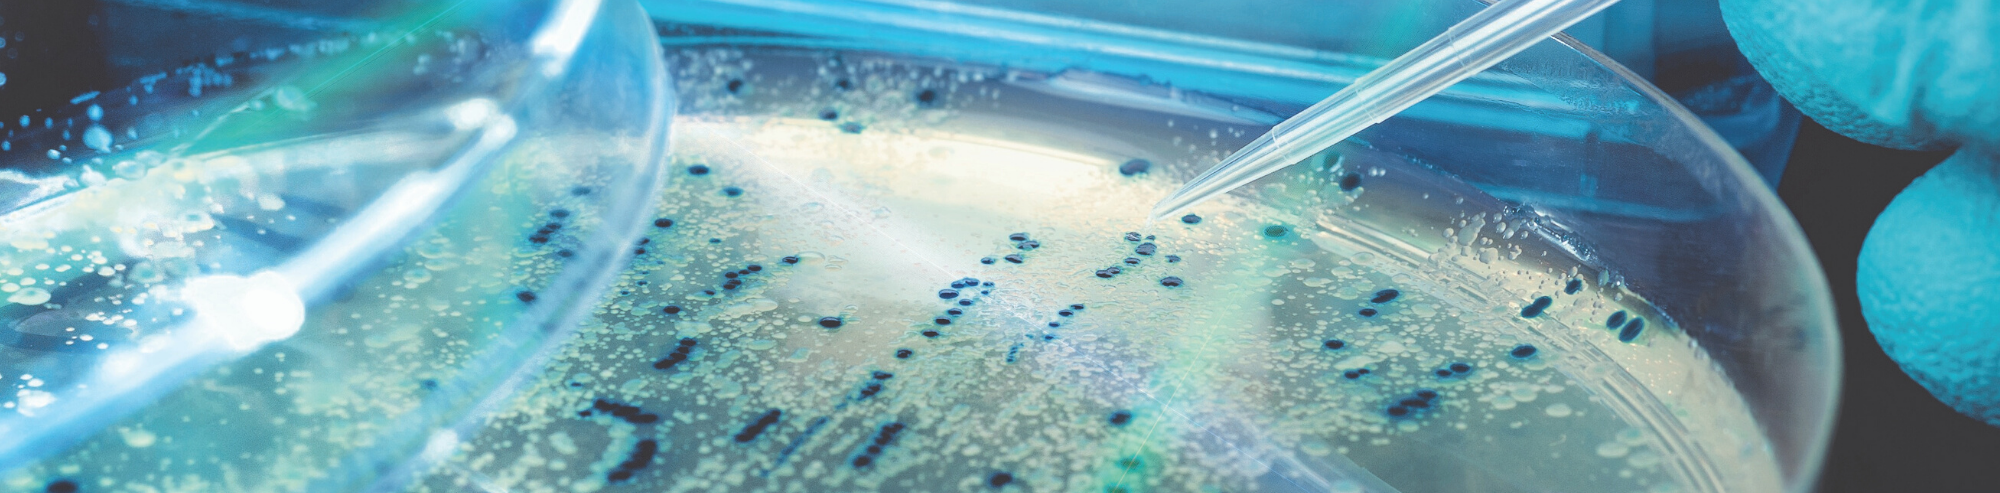
How Do Bacteria Develop Antibiotic Resistance?

A Quick Guide to Literary Research
At this point, we’ve become very aware that good sources for our papers are peer-reviewed sources. That’s easy enough. The daunting part is finding those...


At this point, we’ve become very aware that good sources for our papers are peer-reviewed sources. That’s easy enough. The daunting part is finding those...

An effective introduction section of a scientific article will form a good first impression by the readers or reviewers. This introduction section contains background information...

You’ve probably learned about the Asian giant hornet by its nickname, the “murder hornet” from the news. Asian giant hornets get their intimidating nickname from...

What are Satellite Colonies? While screening bacterial colonies using antibiotic selection pressure, you may notice a few small colonies growing around a large colony on...
An antibiotic is an antimicrobial chemical that kills or inhibits the growth of microorganisms. Antibiotics have been used for a long time to cure many...

Gel electrophoresis is a molecular biology method used to analyze and separate DNA fragments based on their size. When you use gel electrophoresis to help...

In all of its grandeur, polymerase chain reaction (PCR) grants scientists power over genome. Generating ample supply of DNA segments from relatively small samples, PCR...

In molecular biology, the real-time quantitative PCR (qPCR) method is a favorite research tool for many scientists. This method is relatively easy to prepare, fast,...

The first thing a person doing literary research will see is a research publication title. After that, it’s the abstract. These are the first tools...

What are lyophilized reagents Lyophilization, or freeze-drying, is a preservation process that removes water from material in order to further shelf life and stability. Methods...

Who has time for practice? Mostly no one, not when it comes to manuscript writing anyway. But in case that time comes up, or you...

With social media platforms such as Twitter, Instagram, Reddit, YouTube and Facebook, more scientists and science hobbyists are entering the scene as overall promoters of...
